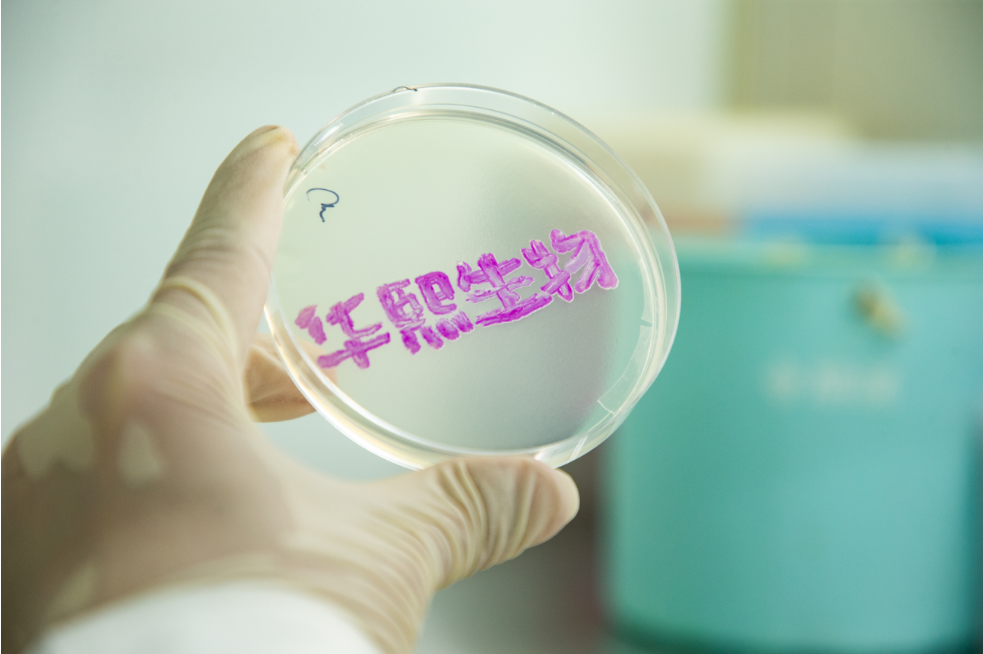
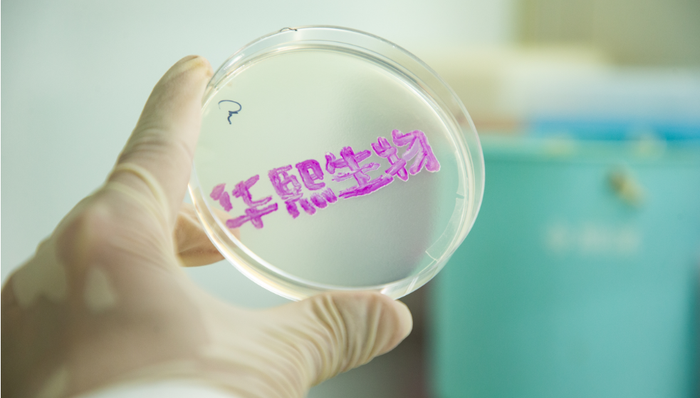
华熙生物组织变革进行时:短期压力下的长期战略博弈

3月3日晚间,华熙生物官方公众号发布了一篇以“从严治理组织、重返业务一线、重回创业状态”为主题的演讲文章,公布了公司董事长赵燕在总裁办公会上的讲话全文。
赵燕在会上强调:“目前华熙生物依然没有走出危机,这种危机并不是因为业绩的下滑,相反......危机在于现有组织的熵增远远超过了这个时代允许的速度,已经到了必须出重手整顿的时候。”
这一次,华熙生物刀尖向内,从具体的人员入手,“所有贪腐人员无论职务高低,必须在3月31日前限时交代问题、提交辞呈。如超过时间未主动交代的,将移交司法部门,不做内部处理。”
3月4日,华熙生物回应界面新闻称:“从严治理组织是华熙生物董事会的一贯要求,近期更是被董事长赵总反复提及,从严治理组织包括对生命科学的长期信仰、对专业的追求和坚持,以及清廉高效的组织人才建设。对以上几方面的程度和评估,我们没有一个精准的答案,但有一点是肯定的:赵总对以上三点的现状并不满意,所以才提出明确的要求。我们相信只有在永不满足的创始人的推动下,一个公司才能不断自我迭代,自我焕新。”
此外,根据赵燕的提议,原华熙生物“个人健康消费品事业部”将更名为“皮肤科学创新转化事业部”。华熙生物回应称:“基于公司的科学底色以及科研优势,我们有能力且有责任去在皮肤科学领域进行科学创新,以及将实验室里的成果转化为市场及大众所需要的好产品。关于华熙生物‘个人健康消费品事业部’将更名为‘皮肤科学创新转化事业部’,后续也将会开展相关的组织及业务调整,以更好的顺应行业的趋势发展以及市场的需求。”
作为中国生物科技领域的龙头企业,华熙生物的一举一动牵动着行业神经。然而,透过表象看本质,这场看似“刮骨疗毒”的变革,实则是公司以长期主义为锚点,主动打破熵增、重构核心竞争力的战略抉择。

熵增危机下的主动变革
2024年被华熙生物定义为“变革元年”,公司通过一系列战略调整和内部改革推动转型升级。华熙生物聘请了全球知名的IBM管理咨询团队进行此次的管理变革。IBM对公司进行全面调研及系统诊断,经过充分的论证和调研,IBM陪伴式的深度进入公司,帮助公司梳理明确变革目标、变革路径、变革办法。
2024年,华熙生物展开了深度变革。但赵燕指出,“这一阶段的流程调整只是把公司失控的动作纠正过来,暴露很多原来没有暴露的问题,真正的变革是人的变革,现在刚刚开始。”
刚刚过去的2月,华熙生物公布了2024年业绩快报,公司营业总收入约53.7亿元,同比下滑11.6%;归属于母公司所有者的净利润约为1.64亿元,同比下滑72.27%。尤其是功能性护肤品业务板块因市场竞争加剧、产业周期波动以及战略调整等因素出现下滑。
市场质疑,华熙生物的变革似乎没有起到作用,相较2023年,华熙生物的业绩并未有太大起色。实际上,2023年华熙生物的C端业务未能延续以往的增长态势、出现较大波动的时候,市场就在怀疑华熙生物的C端业务出现了问题。当时,赵燕曾直言,她认为公司原来的增长模式出现了一些问题,如果华熙生物不主动调整与变革,公司业绩仍会跟随惯性向前发展,问题不会在2023年就显露得那么明显。
早在2021年,赵燕就已经对医美业务主动“踩刹车”,“如果我们不主动变革,踩上一脚刹车,去解决存在的问题,积累下去会出现更大的问题,公司很难长远发展,我们的变革就是要从高速发展转向高质量发展。”华熙生物的医美业务板块在经过变革之后,已经连续三年业务发展持续向好。
华熙生物的消费品业务面临最大的问题是如何独立于企业品牌发展出消费品品牌。赵燕表示,尽管华熙生物有2个品牌达到了5-10亿的规模,2个超过了10亿的量级,但这些品牌更大的关联还是华熙生物这个企业品牌的相关品牌。各品牌在营销生态、营销组织和科技沟通方面还有很大的改善空间,而这样的变革,需要严密的贯彻战略,需要夯实文化和团队,自然也会调整原有的流程和团队。
无论是2024年的流程调整,还是2025年的组织治理,在华熙生物的变革路径上实则是一脉相承。华熙生物近两年的业绩不尽如人意,一部分是市场的原因,更主要的原因是赵燕意识到组织、人才没有跟上时代的变化而主动踩了刹车。
赵燕也认为华熙生物到现在为止依然没有走出危机,但是这种危机却不是因为业绩的下滑,而是现有组织的熵增远远超过了这个时代允许的速度,已经到了必须出重手整顿的时候。简单点来说,这种“危机”并非源于外部竞争或技术落后,而是高速发展过程中积累的组织惰性与管理冗余。
从长期主义视角看,组织熵增是高速发展企业的普遍困境。过去十年,华熙生物从透明质酸原料龙头蜕变为覆盖原料、医美、护肤品、功能性食品的全产业链巨头,市值一度突破千亿。但规模扩张的同时,官僚主义、资源依赖、人才冗余等问题逐渐显现。这种“大公司病”直接导致战略执行偏差,没有得到完全贯彻。
赵燕在上述讲话中指出:“我们是生物科技公司,我们的一切产品应该从生命科学逻辑出发去找增长点。但团队里不少人不但没有思路,还不努力去学习,只会打着市场的旗号去追热点。”对于追热点这一短视行为,赵燕曾表示:“纵观任何一个市场的商业形态,没有一个热点能永远的热下去,而且营销卖点、宣传热点,不等于产业真实的增长点,不等于技术的起步点和落脚点。”
这一年,赵燕强调“核心工作要从简单蹭风口、简单组合和外包模式彻底转向团队自身能力的建设,外包只能在提升效率、发展生态和开放交流这三种目的下才可以发生。必须在相关管理岗位的人能拿出自己的思路的情况下才能推动。”她认为,降低费用率只是表面的问题,为组织培养长期竞争力才是更长远的考量。
华熙生物第一阶段变革中的流程调整主要目的是让问题暴露出来,下一步的重点则是打破低效官僚团队的伪工作,重新建立创业型组织,重新培养创业型团队精神。赵燕也表示会身先士卒,“从过去对研发端为主的工作走到经营工作的一线,尤其是消费品经营工作的一线,补上从科研产品到品牌的后端链路。”
短期阵痛与长期红利
若从短期来看,华熙生物的业绩确实面临着诸多压力,在市场的波动中略显疲态。但是,在短期业绩阵痛背后,华熙生物正以刮骨疗毒的勇气,为下一个十年埋下技术、组织与生态的种子。
在变革过程中,华熙生物投入大量资金用于组织架构升级、薪酬体系变革、咨询服务以及股权激励等管理变革,费用超过7000万元。同时,公司在供应链改造、生产效率提升、智能化建设以及多地产能布局等方面的投入超过1亿元,战略性创新业务投入也超1亿元,还对存在减值迹象的相关资产计提了约2.1亿元的大额减值准备。这些投入虽然在短期内给业绩带来压力,但从长远来看,却为公司的持续增长奠定了坚实基础。
从华熙生物的发展轨迹来看,其过往积累的深厚底蕴为应对当下困境提供了坚实的基础。2024年,华熙生物的原料业务和医疗终端业务在变革中保持了稳健增长,其中原料业务在国际化战略推动下,销量在欧洲、日本、美洲等地持续攀升,进一步巩固了其在全球生物活性物市场的领先地位;医疗终端业务也因旗下医美品牌润致推出新品而保持高速增长。
另外,基于积累的三大核心能力——研发创新能力、成果转换能力、市场转化能力,华熙生物正在进行新一轮的战略升级,即从生物学基础研究出发,聚焦糖生物学和细胞生物学这两大基础学科,依靠合成生物领域的产业转化优势,为生命健康提供科学解决方案。并从生物材料的上游研发开始,从原料生产贯通到品牌建设,探索一条生物材料全链路转化的路径。
此次的战略升级,对于华熙生物而言,是一场全方位的深度变革,涵盖了从理念到实践、从技术到产品、从市场到产业的每一个关键环节,既是为了进一步提升自身的核心竞争力,巩固其在行业内的领先地位;更是为了满足全球消费者对于高品质、高效能生命健康产品和服务的迫切需求,致力于推动生物科技与大健康产业的协同创新发展,为人类健康事业贡献更多力量。
赵燕曾在公开讲话中谈到,华熙生物的企业发展逻辑是从科学、到技术、到产品、到品牌。其中,科学技术是贯穿华熙生物企业发展的基础研究和应用基础研究,是华熙生物的底层支撑、核心驱动。2017年至2023年,华熙生物的研发支出从0.9亿元增长至4.46亿元,年复合增长率达30.57%;截至2023年年底,公司研发团队共计926人,拥有多位核心技术人员;在专利申请方面,截至2023年年底,公司已申请专利908项(含发明专利716项),其中已获授权专利452项。
而华熙生物在研发创新上的持续投入,正逐渐转化为新的竞争力。华熙生物聚焦糖生物学和细胞生物学两大基础学科,在合成生物领域不断探索,取得了一系列重要成果。例如,在透明质酸领域的技术突破,使其能够精准控制分子量,从而拓展了产品在医疗、护肤等多个领域的应用范围。基于这些研究成果,公司开发出了一系列具有创新性的产品,如再生医学领域的润百颜BloomCell细胞营养液、夸迪新一代CT50细胞能量液等,这些新产品有望在未来成为公司新的业绩增长点。
成果转换能力是华熙生物的又一核心竞争力。2024年,天津中试成果转化中心的落成,标志着华熙生物在成果转化方面迈出了关键一步。这座全球规模最大的中试成果转化平台,拥有64条中试生产线,通过“模块化”和“抽屉式”的先进设计理念,极大地优化了中试环节。它不仅能够承接医药级、护肤品级、食品级等多种生物活性物原料产品的中试及小规模商业化生产,还具备“平台化”和“柔性化”的显著特点。
“平台化”意味着它能为众多物质提供全面的中试解决方案,有效加速科研成果的商业化进程;“柔性化”则使其能够灵活适应不同性质、不同工艺的流程切换,实现多产品、多流程、多形态及多单元间的高效转换和生产。
2024年,该平台已成功完成18个项目,包括2个外部项目和16个内部项目;到2025年,在研项目更是达到20余项。借助这个平台,华熙生物助力外部项目实现从百升级至吨级规模的放大及技术优化,还帮助食品领域初创企业完成生产规模的扩大,并在工艺优化方面提供专业赋能。
凭借强大的市场转化能力,华熙生物构建起了从生物活性材料原料到医疗终端产品、功能性护肤品、功能性食品的全产业链业务体系。华熙生物的产品广泛应用于全球的医药、化妆品、食品等多个领域,服务于各类制造企业、医疗机构及终端用户。
在国内,华熙生物在济南、天津、海南、巢湖、东营、湘潭等地布局了各具特色的生产基地;在国外,华熙生物在美国、法国、日本、韩国、新加坡设立了海外子公司,实现了全球范围内的高质量快速触达。以2024年9月投产的湘潭生产基地为例,该基地按照工业4.0标准打造,总投资数亿元,拥有1.5万平方米的现代化厂房,涵盖医疗器械万级洁净生产车间及实验室。
湘潭生产基地主要专注于医疗终端产品的生产,产品范围广泛,包括注射用交联透明质酸钠、透明质酸钠凝胶、医用生物胶等一系列医疗器械产品。基地引入了先进的自动化生产系统,实现整线自动化生产,并构建了可持续的生物智造供应链体系。
目前,湘潭生产基地已成功获得ISO13485认证证书,取得14个二类医疗器械产品的注册证,还在全球率先推出依克多因医疗器械产品。预计该基地年产值将超数亿元,年产能可观,为华熙生物在医疗终端市场的进一步拓展提供了有力保障。
短期的争议,源于人们对不确定性的担忧;而长期的价值,往往在克服争议与困难后才得以彰显。华熙生物过往凭借敏锐的市场洞察力和强大的执行力,在透明质酸领域取得了瞩目的成就,这证明了其决策层的战略眼光和领导能力。此次组织变革,同样是基于对行业趋势的深刻理解和对自身发展瓶颈的清醒认识。
若把目光放长远,就会发现这些变革举措与华熙生物的战略升级相辅相成。通过优化组织架构,能更好地整合研发创新、成果转化和市场转化的资源,提升整体运营效率。未来,随着新组织模式的逐步成熟,华熙生物有望在市场竞争中展现出更强的韧性和爆发力。

评论